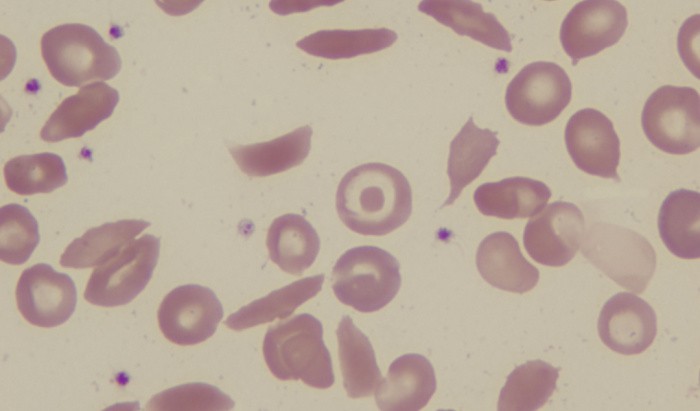
sickle

“All Our Stories” a major new exhibition at the Migration Museum in Lewisham spotlights how migration has shaped who we are in Britain and the NHS – as individuals, as communities and as a nation. Over the decades, the National Health Service has faced huge pressures, rarely more so than today. From the very beginning, […]
“All Our Stories” a major new exhibition